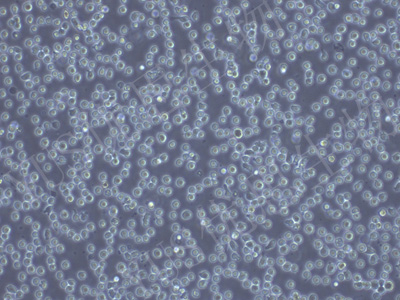
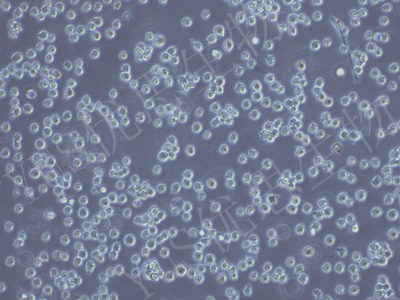

产品中心
产品中心
-
SU-DHL-1 人间变性大细胞淋巴瘤细胞(STR鉴定)
货号:YLH616规格: 1*10^6 -

SVCT 人乳腺上皮细胞(STR鉴定)
货号:YLH617规格: 1*10^6 -

SU-DHL-8 人B细胞淋巴瘤细胞(STR鉴定)
货号:YLH618规格: 1*10^6 -

SK-GT-4 人食道癌肿瘤细胞(STR鉴定)
货号:YLH619规格: 1*10^6 -

NCI-H1693 人肺腺癌细胞(STR鉴定)
货号:YLH620规格: 1*10^6 -

HS-27A 人骨髓细胞(STR鉴定)
货号:YLH621规格: 1*10^6 -

Lu-65 人大细胞肺癌细胞(STR鉴定)
货号:YLH622规格: 1*10^6 -

NCI-H1993 人非小细胞肺癌腺癌细胞(STR鉴定)
货号:YLH623规格: 1*10^6 -

VMM39 人黑色素瘤细胞(STR鉴定)
货号:YLH624规格: 1*10^6 -

Panc 02.13 人胰腺癌细胞(STR鉴定)
货号:YLH625规格: 1*10^6 -

ECC12 人小细胞胃癌细胞(STR鉴定)
货号:YLH628规格: 1*10^6 -
THP-1-GFP 人单核细胞白血病(绿色荧光蛋白标记)(STR鉴定)
货号:YLH629规格: 1*10^6
在线咨询
Online consultation

关注微信公众号


